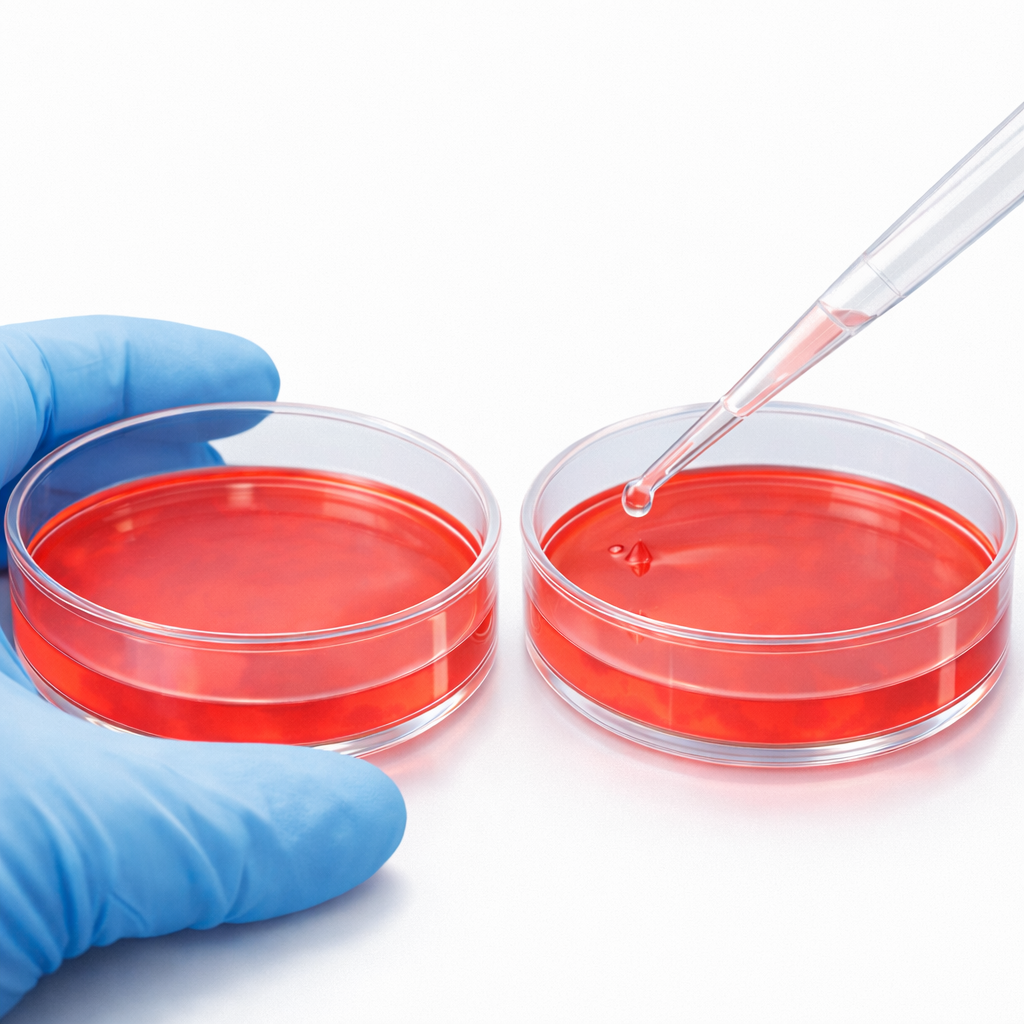

試験概要
OlinkのPEAの技術を用いることでタンパク質を網羅的に定量する事が可能となります。
・お客様の「生体サンプル」をお預かりし、Olink の技術(PEA)を使って 網羅的なタンパク質定量解析(プロテオーム解析) を代行する受託サービスです。
・測定可能なサンプル形式は多様です。たとえば、血清、血漿(EDTA/クエン酸/ヘパリン)、組織溶解物、細胞培養上清、尿、脳脊髄液、滑液、微量生体試料(細針生検、乾燥血液スポットなど)、細胞破砕液、細胞外小胞 などです。
PEAによる定量の特徴
「PEA(Proximity Extension Assay)」とは、対象タンパク質に対して オリゴヌクレオチド標識抗体ペアを使う手法です。

二本の抗体が同じターゲットに近接して結合することで、オリゴ同士がハイブリダイズします。


DNAを伸長して、専用のリアルタイムPCR装置(Signature Q100) や 次世代シーケンサー(NovaSeq 600システム)で読み取ります。

これにより、非常に少量のサンプル(1–6 µL 程度)で、多数のタンパク質を同時に高感度で測定できます。
特異性が高く定量できるのが大きな強みです。

・専用リアルタイムPCR装置 Signature Q100

・次世代シーケンサー NovaSeq 600システム
プラン
下記の3つのプランがあります。
| プラン名 | 主な特徴 |
| Olink Explore HT | 5,400種類以上のタンパク質をターゲットとします。広いダイナミックレンジと高い特異性(99.5%)を誇ります。サンプル量は2µLです。 次世代シーケンサー(NovaSeq 600システム)にて解析します。 |
| Olink Target 96/Olink Target 48 | 43~92種類のタンパク質パネル。サンプル量1µL。絶対定量と相対定量の両方に対応。厳密に検証済み。 専用リアルタイムPCR装置(Signature Q100)にて解析します。 |
| Olink Flex | 15~21のターゲットからなる小規模パネル。サンプル容量は1µL。絶対定量と相対定量の両方に対応。厳密に検証済み。 専用リアルタイムPCR装置(Signature Q100)にて解析します。 |
※各パネルで検出可能なタンパク質はこちらご参照ください。
下記に対象とする主な領域を書きます。
・心臓代謝疾患、炎症性疾患、神経疾患、腫瘍性疾患、循環器、腫瘍、腫瘍免疫、神経、炎症、メタボリズムなど
細胞試験への応用
各種培養細胞にお客様のサンプルを添加して、培養上清や細胞そのものから回収します。
この培養上清や細胞そのものからの抽出液をOlinkのプロテオーム解析でタンパク定量する事も可能です。
例えば血管内皮細胞を培養するとします。
そこへお客様のサンプルを添加した場合としなかった場合の両方を培養します。
両方の培養上清を回収します。
両方の培養上清中のタンパク質をOlinkによって解析する事によって、その比較からお客様のサンプルが血管内皮細胞のタンパク質発現においてどのような効果があったのかが分かります。

お気軽にお問合せ下さい。
※博士号保持者が中心となって試験を担当します。

